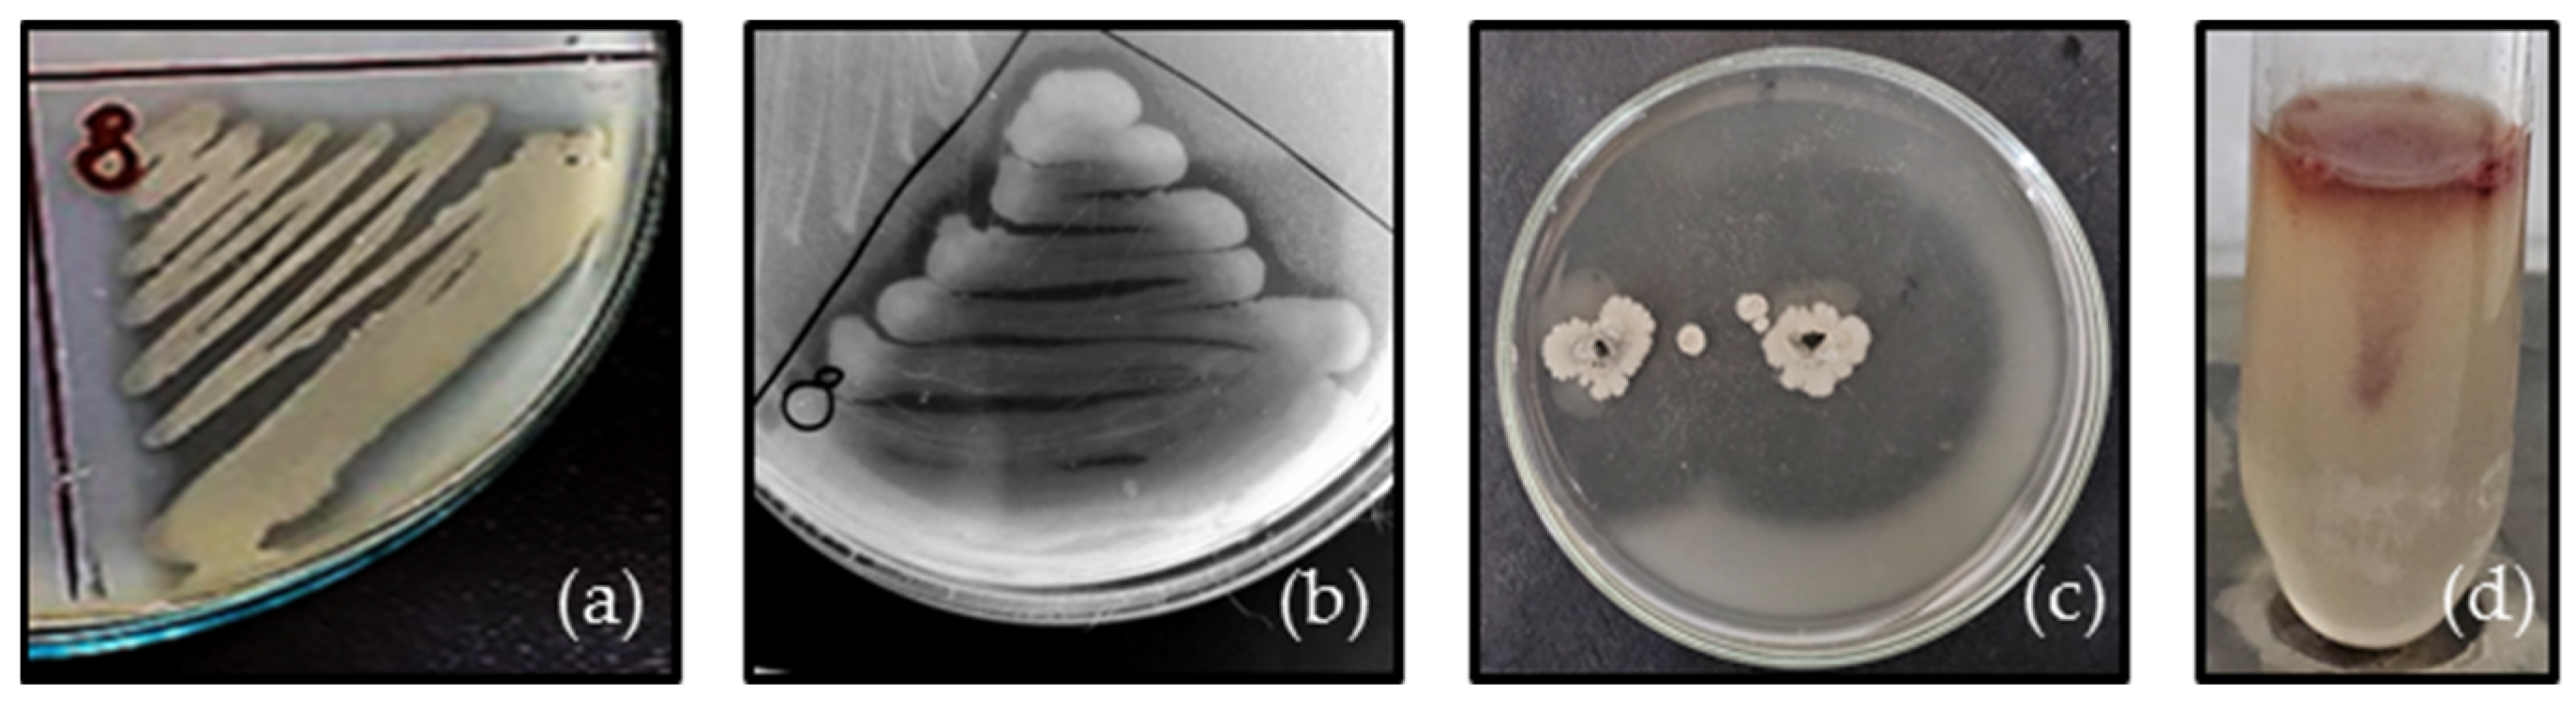
Applmicrobiol 04 00096 g003 Applmicrobiol 04 00096 g003

The Isolation, Identification and Characterization of a Wild-Type Strain Pseudomonas aeruginosa PM1012 from the Cloacal Microbiota of a Common Wall Lizard (Podarcis muralis Laurenti, 1768)
Abstract
1. Introduction
2. Materials and Methods
2.1. Isolation and Identification
2.2. PCR Analysis
2.3. Cultivation at Different Temperatures, pH and Salinity
2.4. Antibiotic Susceptibility Testing (AST)
2.5. Estimation of Exoenzyme Activity, Motility and Pigment Production
2.6. Crystal Violet Assay
2.7. Confocal Laser Scanning Microscopy (CLSM)
3. Results
3.1. Identification
3.2. Effect of Temperature, pH and Salinity on Bacterial Growth
3.3. Antibiotic Susceptibility
3.4. Expression of Virulence Factors
3.4.1. Extracellular Enzyme Production
3.4.2. Pigment Production
3.5. Biofilm Formation
3.5.1. Effect of Temperature on Biofilm Formation
3.5.2. Effect of Temperature on Biofilm Viability and Architecture
4. Discussion
5. Conclusions
Supplementary Materials
Author Contributions
Funding
Institutional Review Board Statement
Data Availability Statement
Conflicts of Interest
References
- Diggle, S.; Whiteley, M. Microbe Profile: Pseudomonas aeruginosa: Opportunistic pathogen and lab rat. Microbiology 2020, 166, 30–33. [Google Scholar] [CrossRef] [PubMed]
- LaBauve, A.; Wargo, M. Growth and Laboratory Maintenance of Pseudomonas aeruginosa. Curr. Protoc. Microbiol. 2012, 25, 6E.1.1–6E.1.8. [Google Scholar] [CrossRef] [PubMed]
- Walker, T.; Bais, H.; Déziel, E.; Schweizer, H.; Rahme, L.; Fall, R.; Vivanco, J. Pseudomonas aeruginosa-Plant Root Interactions. Pathogenicity, Biofilm Formation, and Root Exudation. Plant Physiol. 2004, 134, 320–333. [Google Scholar] [CrossRef] [PubMed]
- Lupo, A.; Haenni, M.; Madec, J.Y. Antimicrobial resistance in Acinetobacter spp. and Pseudomonas spp. Microbiol. Spectr. 2018, 6, 377–393. [Google Scholar] [CrossRef] [PubMed]
- Morales-Espinosa, R.; Delgado, G.; Espinosa-Camacho, F.; Flores-Alanis, A.; Rodriguez, C.; Mendez, J.L.; Gonzalez-Pedraza, A.; Cravioto, A. Pseudomonas aeruginosa strains isolated from animal with high virulence genes content and highly sensitive to antimicrobials. J. Glob. Antimicrob. Resist. 2024, 37, 75–80. [Google Scholar] [CrossRef]
- Malhotra, S.; Hayes, D., Jr.; Wozniak, D.J. Cystic fibrosis and Pseudomonas aeruginosa: The host-microbe interface. Clin. Microbiol. Rev. 2019, 32, e00138-18. [Google Scholar] [CrossRef]
- Qin, S.; Xiao, W.; Zhou, C.; Pu, Q.; Deng, X.; Lan, L.; Liang, H.; Song, X.; Wu, M. Pseudomonas aeruginosa: Pathogenesis, virulence factors, antibiotic resistance, interaction with host, technology advances and emerging therapeutics. Signal Transduct. Target Ther. 2022, 7, 199. [Google Scholar] [CrossRef]
- Elfadadny, A.; Ragab, R.; Al Harbi, M.; Badshah, F.; Ibáñez-Arancibia, E.; Farag, A.; Hendawy, A.; De los Ríos-Escalante, P.R.; Aboubakr, M.; Zakai, S.; et al. Antimicrobial resistance of Pseudomonas aeruginosa: Navigating clinical impacts, current resistance trends, and innovations in breaking therapies. Front. Microbiol. 2024, 15, 1374466. [Google Scholar] [CrossRef]
- Liao, C.; Huang, X.; Wang, Q.; Yao, D.; Lu, W. Virulence Factors of Pseudomonas aeruginosa and Antivirulence Strategies to Combat Its Drug Resistance. Front. Cell. Infect. Microbiol. 2022, 12, 926758. [Google Scholar] [CrossRef]
- Edward, E.A.; El Shehawy, M.R.; Abouelfetouh, A.; Aboulmagd, E. Prevalence of different virulence factors and their association with antimicrobial resistance among Pseudomonas aeruginosa clinical isolates from Egypt. BMC Microbiol. 2023, 23, 161. [Google Scholar] [CrossRef]
- Weimann, A.; Dinan, A.; Ruis, C.; Bernut, A.; Pont, S.; Brown, K.; Ryanm, J.; Santos, L.; Ellison, L.; Ukor, E.; et al. Evolution and host-specific adaptation of Pseudomonas aeruginosa. Science 2024, 385, eadi0908. [Google Scholar] [CrossRef] [PubMed]
- Eliasi, U.; Sebola, D.; Oguttu, J.; Qekwana, D. Antimicrobial resistance patterns of Pseudomonas aeruginosa isolated from canine clinical cases at a veterinary academic hospital in South Africa. J. South Afr. Vet. Assoc. 2020, 91, 1–6. [Google Scholar] [CrossRef]
- Gigante, A.; Hadis, M.; Secker, B.; Shaw, S.; Cooper, P.; Palin, W.; Milward, M.; Atterbury, R. Exposure to blue light reduces antimicrobial resistant Pseudomonas aeruginosa isolated from dog ear infections. Front. Microbiol. 2024, 15, 1414412. [Google Scholar] [CrossRef] [PubMed]
- Salomonsen, C.; Themudo, G.; Jelsbak, L.; Molin, S.; Høiby, N.; Hammer, A. Typing of Pseudomonas aeruginosa from hemorrhagic pneumonia in mink (Neovison vison). Vet. Microbiol. 2013, 163, 103–109. [Google Scholar] [CrossRef] [PubMed]
- Bai, J.; Wang, X.; Zhang, Z.; Lian, P.; Qiao, J. Overview of Mink Immunity and Resistance to Pseudomonas aeruginosa. Vet. Med. Int. 2023, 1, 6158844. [Google Scholar] [CrossRef]
- Schauer, B.; Wald, R.; Urbantke, V.; Loncaric, I.; Baumgartner, M. Tracing Mastitis Pathogens -Epidemiological Investigations of a Pseudomonas aeruginosa Mastitis Outbreak in an Austrian Dairy Herd. Animals 2021, 11, 279. [Google Scholar] [CrossRef]
- Abd El-Ghany, W. Pseudomonas aeruginosa infection of avian origin: Zoonosis and one health implications. Vet. World 2021, 14, 2155–2159. [Google Scholar] [CrossRef]
- Ebani, V.; Fratini, F.; Ampola, M.; Rizzo, E.; Cerri, D.; Andreani, E. Pseudomonas and Aeromonas isolates from domestic reptiles and study of their antimicrobial in vitro sensitivity. Vet. Res. Commun. 2008, 32, 195–198. [Google Scholar] [CrossRef]
- Divers, S. Bacterial Diseases of Reptiles, MSD Veterinary Manual. 2022. Available online: https://www.msdvetmanual.com/exotic-and-laboratory-animals/reptiles/bacterial-diseases-of-reptiles (accessed on 22 February 2024).
- Sala, A.; Di Ianni, F.; Pelizzone, I.; Bertocchi, M.; Santospirito, D.; Rogato, F.; Flisi, S.; Spadini, C.; Iemmi, T.; Moggia, E.; et al. The prevalence of Pseudomonas aeruginosa and multidrug resistant Pseudomonas aeruginosa in healthy captive ophidian. PeerJ 2019, 7, e6706. [Google Scholar] [CrossRef]
- Batista, A.; Pereira, L.; de Melo Neto, J.; dos Santos, T.; de Souza Araújo, Í.; da Silva, J.; Júnior, F. Vesicular dermatitis caused by multiresistent Pseudomonas spp. in the carpet python (Morelia spilota Lacepede, 1804) (Squamata: Pythonidae)—Case report. Res. Soc. Dev. 2021, 10, e205101320966. [Google Scholar] [CrossRef]
- Martins, N.; Ferreira, L.; Queiroz, C.; Buiatte, A.; Lima, A.; De Souza, R.; Oliveira, W., Jr.; Santos, A. Caseous stomatitis caused by Pseudomonas aeruginosa in Boa constrictor amarali. Acta Sci. Vet. 2021, 49, 615. [Google Scholar] [CrossRef]
- Šupić, J.; Rešidbegović, E.; Koro, A.; Hadžiabdić, S.; Golob, M.; Škapur, V.; Alić, A. Fatal Disseminated Pseudomonas aeruginosa Infection in a Captive Green Iguana (Iguana iguana). Acta Vet. 2021, 71, 361–370. [Google Scholar] [CrossRef]
- Xiong, Y.; Wu, Q.; Qin, X.; Yang, C.; Luo, S.; He, J.; Cheng, Q.; Wu, Z. Identification of Pseudomonas aeruginosa from the skin ulcer disease of crocodile lizards (Shinisaurus crocodilurus) and probiotics as the control measure. Front. Vet. Sci. 2022, 9, 850684. [Google Scholar] [CrossRef] [PubMed]
- Liu, P.; Weng, L.; Tseng, S.; Huang, C.; Cheng, C.; Mao, Y.; Tung, K. Colistin resistance of Pseudomonas aeruginosa isolated from snakes in Taiwan. Can. J. Infect. Dis. Med. Microbiol. 2017, 2017, 7058396. [Google Scholar] [CrossRef]
- Foti, M.; Giacopello, C.; Fisichella, V.; Latella, G. Multidrug-resistant Pseudomonas aeruginosa isolates from captive reptiles. J. Exot. Pet Med. 2013, 22, 270–274. [Google Scholar] [CrossRef]
- Muñoz-Ibarra, E.; Molina-López, R.A.; Durán, I.; Garcias, B.; Martín, M.; Darwich, L. Antimicrobial resistance in bacteria isolated from exotic pets: The situation in the Iberian Peninsula. Animals 2022, 125, 1912. [Google Scholar] [CrossRef]
- Wendt, M.; De Silva, B.; Heo, G.J. Virulence Factors and Antimicrobial Resistance of Pseudomonas aeruginosa Isolated from Pet Turtles. Asian J. Anim. Vet. Adv. 2017, 12, 205–211. [Google Scholar] [CrossRef][Green Version]
- Wickramanayake, M.; De Silva, L.; Heo, G.-J. Pseudomonas aeruginosa from pet Chinese stripe-necked turtles (Ocadia sinensis) demonstrating antimicrobial and heavy metal resistance. Vet. Integr. Sci. 2022, 20, 761–773. [Google Scholar] [CrossRef]
- Ruiz-Roldán, L.; Rojo-Bezares, B.; de Toro, M.; López, M.; Toledano, P.; Lozano, C.; Chichon, G.; Alvarez-Erviti, L.; Torres, C.; Saenz, Y. Antimicrobial resistance and virulence of Pseudomonas spp. among healthy animals: Concern about exolysin ExlA detection. Sci. Rep. 2020, 10, 11667. [Google Scholar] [CrossRef]
- Weisburg, W.; Barns, S.; Pelletier, D.; Lane, D. 16S ribosomal DNA amplification for phylogenetic study. J. Bacteriol. 1991, 173, 697–703. [Google Scholar] [CrossRef]
- Hall, T. BioEdit: A user-friendly biological sequence alignment editor and analysis program for Windows 95/98/NT. Nucleic Acids. Symp. Ser. 1999, 41, 95–98. Available online: https://api.semanticscholar.org/CorpusID:82421255 (accessed on 30 January 2024).
- Camacho, C.; Coulouris, G.; Avagyan, V.; Ma, N.; Papadopoulos, J.; Bealer, K.; Madden, T. BLAST+: Architecture and applications. BMC Bioinform. 2009, 10, 421. [Google Scholar] [CrossRef] [PubMed]
- Abel, E.; Evivie, S. Effect of varying environmental conditions on the growth and viability of selected microorganisms using conventional cultures. J. Appl. Sci. Environ. Manag. 2022, 26, 393–397. [Google Scholar] [CrossRef]
- Hudzicki, J. Kirby-Bauer Disk Diffusion Susceptibility Test Protocol, American Society for Microbiology. 2009. Available online: https://asm.org/getattachment/2594ce26-bd44-47f6-8287-0657aa9185ad/Kirby-Bauer-Disk-Diffusion-Susceptibility-Test-Protocol-pdf.pdf (accessed on 11 November 2023).
- CLSI Guidelines M100—M02. In Performance Standards for Antimicrobial Susceptibility Testing, 33rd ed.; Clinical Laboratory Standards Institute: Wayne, PA, USA, 2023.
- The European Committee on Antimicrobial Susceptibility Testing (EUCAST). Breakpoint Tables for Interpretation of MICs and Zone Diameters, Version 14.0. 2024. Available online: http://www.eucast.org (accessed on 14 February 2024).
- dela Cruz, T.; Torres, J. Gelatin Hydrolysis Test Protocol, American Society for Microbiology. 2012. Available online: https://asm.org/ASM/media/Protocol-Images/Gelatin-Hydrolysis-Test-Protocol.pdf?ext=.pdf (accessed on 15 November 2023).
- Uchida, Y.; Tsukada, Y.; Sugimori, T. Distribution of neuraminidase in Arthrobacter and its purification by affinity chromatography. J. Biochem. 1977, 82, 1425–1433. [Google Scholar] [CrossRef] [PubMed]
- Patil, S.; Chaudhari, B. A simple, rapid and sensitive plate assay for detection of microbial hyaluronidase activity. J. Basic Microbiol. 2017, 57, 358–361. [Google Scholar] [CrossRef] [PubMed]
- Brink, B. Urease Test Protocol, American Society for Microbiology. 2010. Available online: https://asm.org/getattachment/ac4fe214-106d-407c-b6c6-e3bb49ac6ffb/urease-test-protocol-3223.pdf (accessed on 9 April 2024).
- Shields, P.; Cathcart, L. Motility Test Medium Protocol, American Society for Microbiology. 2011. Available online: https://asm.org/ASM/media/Protocol-Images/Motility-Test-Medium-Protocol.pdf?ext=.pdf (accessed on 15 April 2024).
- Merritt, J.; Kadouri, D.; O’Toole, G. Growing and analyzing static biofilms. Curr. Protoc. Microbiol. 2005, 1, 853. [Google Scholar] [CrossRef]
- Zhang, P.; Chen, Y.; Qiu, J.; Dai, Y.; Feng, B. Imaging the Microprocesses in Biofilm Matrices. Trends Biotechnol. 2019, 37, 214–226. [Google Scholar] [CrossRef]
- Lazarkevich, I.; Engibarov, S.; Mitova, S.; Popova, S.; Vacheva, E.; Stanchev, N.; Eneva, R.; Gocheva, Y.; Lalovska, I.; Paunova-Krasteva, T.; et al. Pathogenic Potential of Opportunistic Gram-Negative Bacteria Isolated from the Cloacal Microbiota of Free-Living Reptile Hosts Originating from Bulgaria. Life 2024, 14, 566. [Google Scholar] [CrossRef]
- Magiorakos, A.; Srinivasan, A.; Carey, R.; Carmeli, Y.; Falagas, M.; Giske, C.; Harbarth, S.; Hindler, J.; Kahlmeter, G.; Olsson-Liljequist, B.; et al. Multidrug-resistant, extensively drug-resistant and pandrug-resistant bacteria: An international expert proposal for interim standard definitions for acquired resistance. Clin. Microbiol. Infect. 2012, 18, 268–281. [Google Scholar] [CrossRef]
- Morita, Y.; Tomida, J.; Kawamura, Y. Responses of Pseudomonas aeruginosa to antimicrobials. Front. Microbiol. 2014, 4, 422. [Google Scholar] [CrossRef]
- Strateva, T.; Yordanov, D. Pseudomonas aeruginosa—A phenomenon of bacterial resistance. J. Med. Microbiol. 2009, 58, 1133–1148. [Google Scholar] [CrossRef] [PubMed]
- Avakh, A.; Grant, G.; Cheesman, M.; Kalkundri, T.; Hall, S. The art of war with Pseudomonas aeruginosa: Targeting Mex efflux pumps directly to strategically enhance antipseudomonal drug efficacy. Antibiotics 2023, 12, 1304. [Google Scholar] [CrossRef] [PubMed]
- Afunwa, R.; Ezeanyinka, J.; Afunwa, E.; Udeh, A.; Oli, N.; Unachukwu, M. Multiple Antibiotic Resistant Index of Gram-Negative Bacteria from Bird Droppings in Two Commercial Poultries in Enugu, Nigeria. Open J. Med. Microbiol. 2020, 10, 171–181. [Google Scholar] [CrossRef]
- Bălăşoiu, M.; Bălăşoiu, A.; Mănescu, R.; Avramescu, C.; Ionete, O. Pseudomonas aeruginosa resistance phenotypes and phenotypic highlighting methods. Curr. Health Sci. J. 2014, 40, 85. [Google Scholar] [CrossRef] [PubMed]
- Salvà-Serra, F.; Jaén-Luchoro, D.; Marathe, N.; Adlerberth, I.; Moore, E.; Karlsson, R. Responses of carbapenemase-producing and non-producing carbapenem-resistant Pseudomonas aeruginosa strains to meropenem revealed by quantitative tandem mass spectrometry proteomics. Front. Microbiol. 2023, 13, 1089140. [Google Scholar] [CrossRef]
- Gobezie, M.; Hassen, M.; Tesfaye, N.; Solomon, T.; Demessie, M.; Kassa, T.; Wendie, T.; Andualem, A.; Alemayehu, E.; Belayneh, Y. Prevalence of meropenem-resistant Pseudomonas aeruginosa in Ethiopia: A systematic review and me-ta analysis. Antimicrob. Resist. Infect. Control. 2024, 13, 37. [Google Scholar] [CrossRef]
- Ramsay, K.; Wardell, S.; Patrick, W.; Brockway, B.; Reid, D.; Winstanley, C.; Bell, S.; Lamont, I. Genomic and phenotypic comparison of environmental and patient-derived isolates of Pseudomonas aeruginosa suggest that antimicrobial resistance is rare within the environment. J. Med. Microbiol. 2019, 68, 1591–1595. [Google Scholar] [CrossRef]
- Streeter, K.; Katouli, M. Pseudomonas aeruginosa: A review of their pathogenesis and prevalence in clinical settings and the environment. Infect. Epidemiol. Med. 2016, 2, 25–32. [Google Scholar] [CrossRef]
- Laborda, P.; Sanz-García, F.; Ochoa-Sánchez, L.; Gil-Gil, T.; Hernando-Amado, S.; Martínez, J. Wildlife and antibiotic resistance. Front. Cell. Infec. Microbiol. 2022, 12, 873989. [Google Scholar] [CrossRef]
- Traving, C.; Schauer, R. Structure, function and metabolism of sialic acids. Cell. Mol. Life Sci. 1998, 54, 1330–1349. [Google Scholar] [CrossRef]
- Sangeetha, A.; Abdel-hadi, A.; Hassan, A.; Shobana, C.; Suresh, S.; Abirami, B.; Selvam, K.; Al-Baradie, R.; Banawas, S.; Alaidarous, M.; et al. Evaluation of in vitro activities of extracellular enzymes from Aspergillus species isolated from corneal ulcer/keratitis. Saudi J. Biol. Sci. 2020, 27, 701–705. [Google Scholar] [CrossRef] [PubMed]
- Lantz, M. Are Bacterial proteases important virulence factors? J. Periodontal Res. 1997, 32, 126–132. [Google Scholar] [CrossRef] [PubMed]
- Figaj, D.; Ambroziak, P.; Przepiora, T.; Skorko-Glonek, J. The role of proteases in the virulence of plant pathogenic bacteria. Int. J. Mol. Sci. 2019, 20, 672. [Google Scholar] [CrossRef] [PubMed]
- Zhigis, L.; Kotelnikova, O.; Zinchenko, A.; Karlinsky, D.; Prokopenko, Y.; Rumsh, L. IgA1 protease as a vaccine basis for prevention of bacterial meningitis. Russ. J. Bioorg. Chem. 2021, 47, 805–814. [Google Scholar] [CrossRef]
- Thurlow, L.; Thomas, V.; Narayanan, S.; Olson, S.; Fleming, S.; Hancock, L. Gelatinase contributes to the pathogenesis of endocarditis caused by Enterococcus faecalis. Infect. Immun. 2010, 78, 4936–4943. [Google Scholar] [CrossRef] [PubMed]
- Bender, J.; Flieger, A. Lipases as pathogenicity factors of bacterial pathogens of humans. In Handbook of Hydrocarbon and Lipid Microbiology; Timmis, K., Ed.; Springer: Berlin/Heidelberg, Germany, 2010; pp. 3241–3258. [Google Scholar] [CrossRef]
- Zhang, Z.; Zhang, X. Evolution of Subfamily I.1 Lipases in Pseudomonas aeruginosa. Curr. Microbiol. 2021, 78, 3494–3504. [Google Scholar] [CrossRef]
- Jaeger, K.; Ransac, S.; Dijkstra, B.; Colson, C.; van Heuvel, M.; Misset, O. Bacterial lipases. FEMS Microbiol. Rev. 1994, 15, 29–63. [Google Scholar] [CrossRef]
- Aqel, H.; Sannan, N.; Foudah, R.; Al-Hunaiti, A. Enzyme Production and Inhibitory Potential of Pseudomonas aeruginosa: Contrasting Clinical and Environmental Isolates. Antibiotics 2023, 12, 1354. [Google Scholar] [CrossRef]
- da Cruz Nizer, W.; Inkovskiy, V.; Versey, Z.; Strempel, N.; Cassol, E.; Overhage, J. Oxidative Stress Response in Pseudomonas aeruginosa. Pathogens 2021, 10, 1187. [Google Scholar] [CrossRef]
- Abdelaziz, A.; Kamer, A.; Al-Monofy, K.; Al-Madboly, L. Pseudomonas aeruginosa’s greenish-blue pigment pyocyanin: Its production and biological activities. Microb. Cell Fact. 2023, 22, 110. [Google Scholar] [CrossRef]
- Ho Sui, S.J.; Lo, R.; Fernandes, A.R.; Caulfield, M.D.; Lerman, J.A.; Xie, L.; Bourne, P.E.; Baillie, D.L.; Brinkman, F.S. Raloxifene attenuates Pseudomonas aeruginosa pyocyanin production and virulence. Int. J. Antimicrob. Agents 2012, 40, 246–251. [Google Scholar] [CrossRef] [PubMed]
- Hall, S.; McDermott, C.; Anoopkumar-Dukie, S.; McFarland, A.J.; Forbes, A.; Perkins, A.V.; Davey, A.K.; Chess-Williams, R.; Kiefel, M.J.; Arora, D.; et al. Cellular Effects of Pyocyanin, a Secreted Virulence Factor of Pseudomonas aeruginosa. Toxins 2016, 8, 236. [Google Scholar] [CrossRef] [PubMed]
- Jabłońska, J.; Augustyniak, A.; Dubrowska, K.; Rakoczy, R. The two faces of pyocyanin–why and how to steer its production? World J. Microbiol. Biotechnol. 2023, 39, 103. [Google Scholar] [CrossRef] [PubMed]
- Das, T.; Manefield, M. Pyocyanin Promotes Extracellular DNA Release in Pseudomonas aeruginosa. PLoS ONE 2012, 7, e46718. [Google Scholar] [CrossRef] [PubMed]
- Shouman, H.; Said, H.; Kenawy, H.; Hassan, R. Molecular and biological characterization of pyocyanin from clinical and environmental Pseudomonas aeruginosa. Microb. Cell Fact. 2023, 22, 166. [Google Scholar] [CrossRef]
- Vestby, L.; Grønseth, T.; Simm, R.; Nesse, L. Bacterial biofilm and its role in the pathogenesis of disease. Antibiotics 2020, 9, 59. [Google Scholar] [CrossRef]
- Singh, S.; Singh, S.; Chowdhury, I.; Singh, R. Understanding the mechanism of bacterial biofilms resistance to antimicrobial agents. Open Microbiol. J. 2017, 11, 53–62. [Google Scholar] [CrossRef]
- Bisht, K.; Moore, J.; Caprioli, R.; Skaar, E.; Wakeman, C. Impact of temperature-dependent phage expression on Pseudomonas aeruginosa biofilm formation. Npj Biofilms Microbiomes 2021, 7, 22. [Google Scholar] [CrossRef]
- Al-Khazraji, S.; Al-Maeni, M. Optimization of some environmental and nutritional conditions using microtiter plate for Pseudomonas aeruginosa biofilm formation. J. Anim. Behav. Biometeorol. 2021, 9, 2136. [Google Scholar] [CrossRef]
- Choi, N.; Kim, B.; Bae, Y.; Lee, S. Biofilm formation, attachment, and cell hydrophobicity of foodborne pathogens under varied environmental conditions. J. Korean Soc. Appl. Biol. Chem. 2013, 56, 207–220. [Google Scholar] [CrossRef]
- Iliadis, I.; Daskalopoulou, A.; Simoes, M.; Giaouris, E. Integrated combined effects of temperature, pH and sodium chloride concentration on biofilm formation by Salmonella enterica ser. enteritidis and typhimurium under low nutrient food-related conditions. Food Res. Int. 2018, 107, 10–18. [Google Scholar] [CrossRef] [PubMed]
- De Silva, P.; Chong, P.; Fernando, D.; Westmacott, G.; Kumar, A. Effect of incubation temperature on antibiotic resistance and virulence factors of Acinetobacter baumanii ATCC 17978. Antimicrob. Agents Chemother. 2018, 62, e01514-17. [Google Scholar] [CrossRef] [PubMed]
- Borisova, D.; Jordanova, V.; Stoitsova, S.; Paunova-Krasteva, T. Impact of Growth Conditions on Biofilm Formation by Model Gram- Negative and Gram-Positive Bacterial Strains. Acta Microbiol. Bulg. 2019, 35, 60–65. [Google Scholar]
- Kothari, A.; Kumar, S.K.; Singh, V.; Kumar, P.; Kaushal, K.; Pandey, A.; Jain, N.; Omar, B.J. Association of multidrug resistance behavior of clinical Pseudomonas aeruginosa to pigment coloration. Eur. J. Med. Res. 2022, 27, 120. [Google Scholar] [CrossRef] [PubMed]

Disclaimer/Publisher’s Note: The statements, opinions and data contained in all publications are solely those of the individual author(s) and contributor(s) and not of MDPI and/or the editor(s). MDPI and/or the editor(s) disclaim responsibility for any injury to people or property resulting from any ideas, methods, instructions or products referred to in the content. |
© 2024 by the authors. Licensee MDPI, Basel, Switzerland. This article is an open access article distributed under the terms and conditions of the Creative Commons Attribution (CC BY) license (https://creativecommons.org/licenses/by/4.0/).
Share and Cite
Lazarkevich, I.; Engibarov, S.; Mitova, S.; Eneva, R.; Paunova-Krasteva, T.; Borisova, D.; Vacheva, E.; Stanchev, N.; Popova, S.; Gocheva, Y.; et al. The Isolation, Identification and Characterization of a Wild-Type Strain Pseudomonas aeruginosa PM1012 from the Cloacal Microbiota of a Common Wall Lizard (Podarcis muralis Laurenti, 1768). Appl. Microbiol. 2024, 4, 1396-1410. https://doi.org/10.3390/applmicrobiol4030096
Lazarkevich I, Engibarov S, Mitova S, Eneva R, Paunova-Krasteva T, Borisova D, Vacheva E, Stanchev N, Popova S, Gocheva Y, et al. The Isolation, Identification and Characterization of a Wild-Type Strain Pseudomonas aeruginosa PM1012 from the Cloacal Microbiota of a Common Wall Lizard (Podarcis muralis Laurenti, 1768). Applied Microbiology. 2024; 4(3):1396-1410. https://doi.org/10.3390/applmicrobiol4030096
Chicago/Turabian StyleLazarkevich, Irina, Stephan Engibarov, Simona Mitova, Rumyana Eneva, Tsvetelina Paunova-Krasteva, Dayana Borisova, Emiliya Vacheva, Nikola Stanchev, Steliyana Popova, Yana Gocheva, and et al. 2024. "The Isolation, Identification and Characterization of a Wild-Type Strain Pseudomonas aeruginosa PM1012 from the Cloacal Microbiota of a Common Wall Lizard (Podarcis muralis Laurenti, 1768)" Applied Microbiology 4, no. 3: 1396-1410. https://doi.org/10.3390/applmicrobiol4030096
APA StyleLazarkevich, I., Engibarov, S., Mitova, S., Eneva, R., Paunova-Krasteva, T., Borisova, D., Vacheva, E., Stanchev, N., Popova, S., Gocheva, Y., & Gerginova, M. (2024). The Isolation, Identification and Characterization of a Wild-Type Strain Pseudomonas aeruginosa PM1012 from the Cloacal Microbiota of a Common Wall Lizard (Podarcis muralis Laurenti, 1768). Applied Microbiology, 4(3), 1396-1410. https://doi.org/10.3390/applmicrobiol4030096

